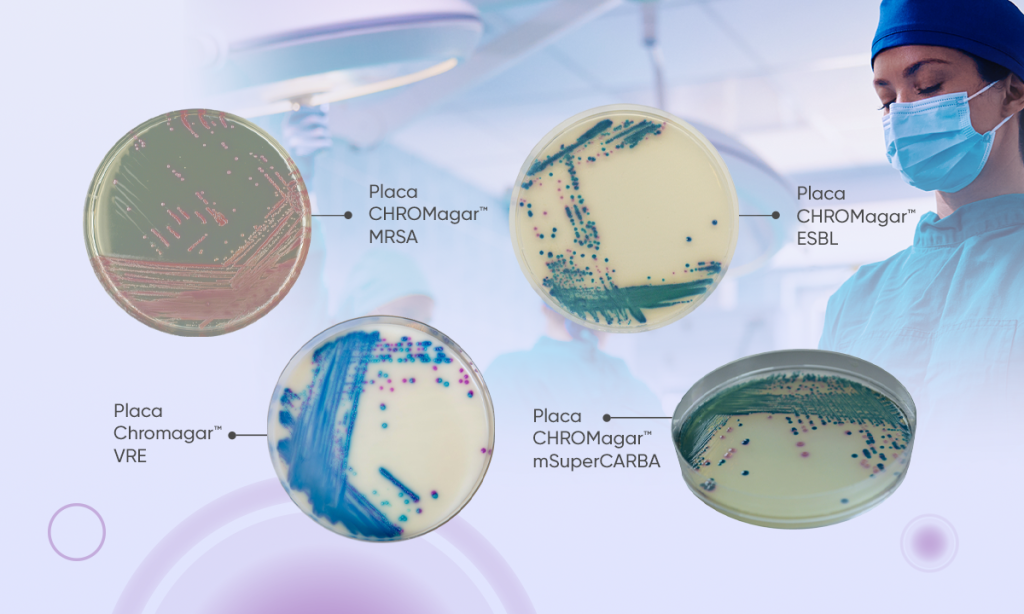
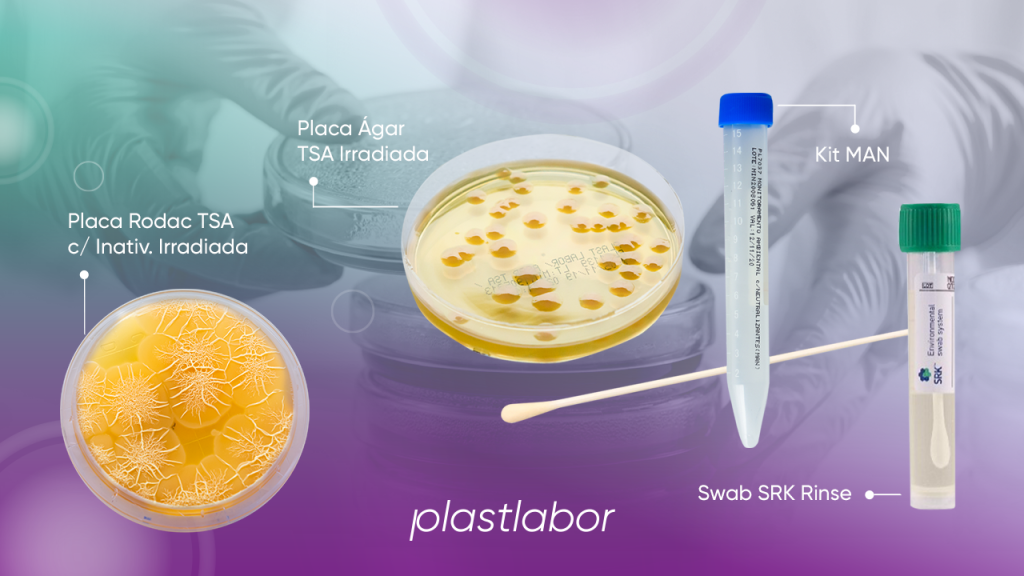
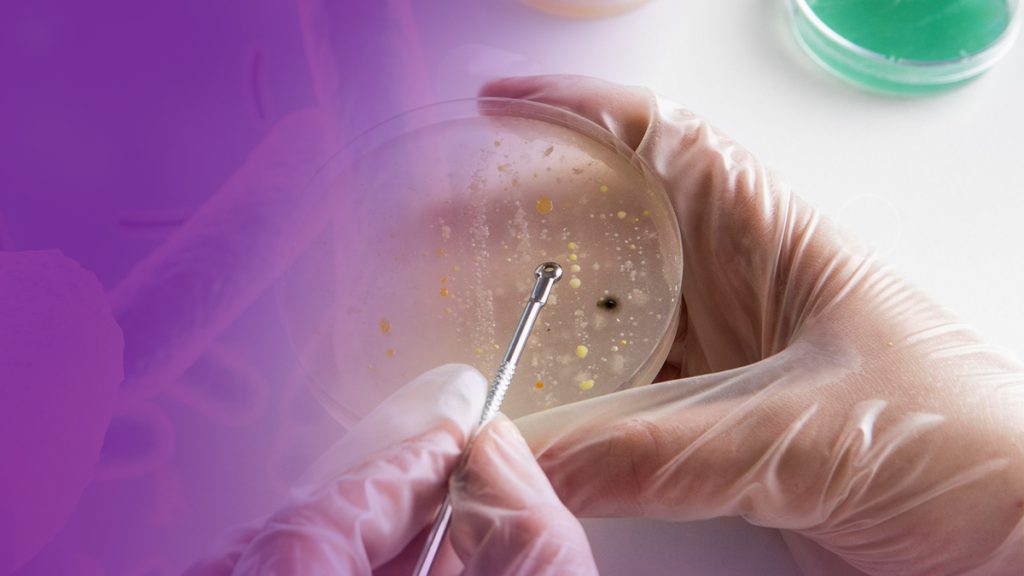

Cultura de Vigilância no Ambiente Hospitalar
As infecções relacionadas à assistência à saúde são uma das complicações mais comumente encontradas em pacientes hospitalizados e representam um grande problema de saúde pública.
Monitoramento Ambiental na Indústria
O Monitoramento Ambiental (MA) relacionado a partículas viáveis e não viáveis, juntamente com o monitoramento dos processos e os operadores envolvidos nas atividades produtivas, compõem parte da estratégia da Indústria em seu Sistema da Qualidade, visando o controle da contaminação dos produtos.
Plastlabor Inicia o Ano com Publicações na Laes&Haes

Com orgulho compartilhamos com vocês a publicação de um artigo notável e a contribuição em uma coluna de opinião na renomada revista Laes&Haes.
Investigação de surto de Salmonella

A Indústria Alimentar está vivenciando um número alarmante de grandes recalls de produtos devido à contaminação microbiana.
Restrospectiva Plastlabor 2023

Ao refletirmos sobre o ano que se encerra, é com grande entusiasmo que relembramos alguns fatos marcantes na Retrospectiva 2023 da Plastlabor.
Controle de Qualidade em Alimentos

O sorotipo O157:H7 de E. coli ou sua variante não móvel O157:H – é o sorotipo VTEC mais comum em relação à saúde pública.
Vencedores do 3º Concurso Ágar Art

O 3º Concurso Ágar Art teve a participação de mais de 50 pessoas, que enviaram 83 imagens. Confira os vencedores.
3º Concurso Ágar Art

Somente os microbiologistas conseguem enxergar a versatilidade e beleza dos fungos, das bactérias e de tantos outros seres microscópios. Com essa máxima, a Plastlabor acaba de lançar a Terceira Edição do Concurso Ágar Art – Plastlabor. Para participar Crie a arte usando seus microrganismos e ágar favoritos. O tema é livre; No formulário, informe os […]
Cuidando do Planeta e da Saúde: One Health

Na interconexão entre seres humanos, animais, meio ambiente e alimentos, um conceito emerge como um farol de cuidado abrangente: o One Health.
Pandemia Silenciosa: Superbactérias no Pacífico
Um recente relatório divulgado pela OMS trouxe à tona uma realidade alarmante na Região do Pacífico Ocidental.
Webinar “Perfil da resistência bacteriana e o impacto do diagnóstico microbiológico na era COVID”

Webinar “Perfil da resistência bacteriana e o impacto do diagnóstico microbiológico na era COVID”.
Rotina de Vigilância

Cultura de Vigilância (ou rastreamento): Detecção de colonização de microrganismos multirresistentes em amostras clínicas.